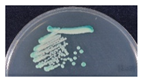
Microorganisms 09 00142 i001 Microorganisms 09 00142 i001
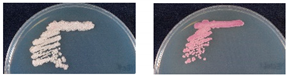
Microorganisms 09 00142 i003 Microorganisms 09 00142 i003
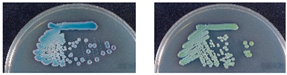
Microorganisms 09 00142 i004 Microorganisms 09 00142 i004
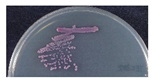
Microorganisms 09 00142 i009 Microorganisms 09 00142 i009
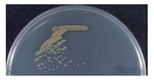
Microorganisms 09 00142 i010 Microorganisms 09 00142 i010

The Use of MALDI-TOF Mass Spectrometry to Analyze Commensal Oral Yeasts in Nursing Home Residents
Abstract
1. Introduction
2. Materials and Methods
2.1. Oral Yeast Isolates
2.2. Bruker MALDI-TOF MS
2.3. Sequence Analysis of Ribosomal DNA
2.4. Statistic Analysis
3. Results
3.1. Isolation and Identification of Oral Yeast
3.2. Accuracy of Bruker MALDI-TOF MS Identification
3.3. Rapid Differentiation of Yeasts by CHROMagar Candida
4. Discussion
4.1. Commensal Oral Yeasts in the Elderly
4.2. Limitation of MALDI-TOF MS, Chromogenic Agar, and Ribosomal DNA Sequencing in Microbial Pathogenesis
4.3. Mycobiome Analysis Using Culture- and Non-Culture Methods
4.4. Using of CHROMagar Candida to Differentiate Yeast Species in the Oral Cavity
4.5. Use of MALDI-TOF MS to Analyze Oral Mycobiome
5. Conclusions
Supplementary Materials
Author Contributions
Funding
Institutional Review Board Statement
Informed Consent Statement
Data Availability Statement
Conflicts of Interest
References
- Van Belkum, A.; Welker, M.; Pincus, D.; Charrier, J.P.; Girard, V. Matrix-assisted laser desorption ionization time-of-flight mass spectrometry in clinical microbiology: What are the current issues? Ann. Lab. Med. 2017, 37, 475–483. [Google Scholar] [CrossRef] [PubMed]
- Wattal, C.; Oberoi, J.K.; Goel, N.; Raveendran, R.; Khanna, S. Matrix-assisted laser desorption ionization time of flight mass spectrometry (MALDI-TOF MS) for rapid identification of micro-organisms in the routine clinical microbiology laboratory. Eur. J. Clin. Microbiol. Infect. Dis. 2017, 36, 807–812. [Google Scholar] [CrossRef] [PubMed]
- Ge, M.C.; Kuo, A.J.; Liu, K.L.; Wen, Y.H.; Chia, J.H.; Chang, P.Y.; Lee, M.H.; Wu, T.L.; Chang, S.C.; Lu, J.J.; et al. Routine identification of microorganisms by matrix-assisted laser desorption ionization time-of-flight mass spectrometry: Success rate, economic analysis, and clinical outcome. J. Microbiol. Immunol. Infect. 2017, 50, 662–668. [Google Scholar] [CrossRef] [PubMed]
- Cassagne, C.; Normand, A.C.; L’Ollivier, C.; Ranque, S.; Piarroux, R. Performance of MALDI-TOF MS platforms for fungal identification. Mycoses 2016, 59, 678–690. [Google Scholar] [CrossRef] [PubMed]
- Pulcrano, G.; Iula, D.V.; Vollaro, A.; Tucci, A.; Cerullo, M.; Esposito, M.; Rossano, F.; Catania, M.R. Rapid and reliable MALDI-TOF mass spectrometry identification of Candida non-albicans isolates from bloodstream infections. J. Microbiol. Methods 2013, 94, 262–266. [Google Scholar] [CrossRef] [PubMed]
- Lagier, J.C.; Khelaifia, S.; Alou, M.T.; Ndongo, S.; Dione, N.; Hugon, P.; Caputo, A.; Cadoret, F.; Traore, S.I.; Seck, E.H.; et al. Culture of previously uncultured members of the human gut microbiota by culturomics. Nat. Microbiol. 2016, 1, 16203. [Google Scholar] [CrossRef]
- Sung, J.Y.; Hwang, Y.; Shin, M.H.; Park, M.S.; Lee, S.H.; Yong, D.; Lee, K. Utility of conventional culture and MALDI-TOF MS for identification of microbial communities in bronchoalveolar lavage fluid in comparison with the Gs junior next generation sequencing system. Ann. Lab. Med. 2018, 38, 110–118. [Google Scholar] [CrossRef]
- United Nations. World Population Ageing 2017: Highlights; United Nations: New York, NY, USA, 2017. [Google Scholar]
- Ogawa, T.; Hirose, Y.; Honda-Ogawa, M.; Sugimoto, M.; Sasaki, S.; Kibi, M.; Kawabata, S.; Ikebe, K.; Maeda, Y. Composition of salivary microbiota in elderly subjects. Sci. Rep. 2018, 8, 414. [Google Scholar] [CrossRef]
- Sender, R.; Fuchs, S.; Milo, R. Are we really vastly outnumbered? Revisiting the ratio of bacterial to host cells in humans. Cell 2016, 164, 337–340. [Google Scholar] [CrossRef]
- Kumar, P.S. Oral microbiota and systemic disease. Anaerobe 2013, 24, 90–93. [Google Scholar] [CrossRef]
- Anil, S.; Anand, P.S. Early childhood caries: Prevalence, risk factors, and prevention. Front. Pediatr. 2017, 5, 157. [Google Scholar] [CrossRef] [PubMed]
- Noguera-Julian, M.; Guillen, Y.; Peterson, J.; Reznik, D.; Harris, E.V.; Joseph, S.J.; Rivera, J.; Kannanganat, S.; Amara, R.; Nguyen, M.L.; et al. Oral microbiome in HIV-associated periodontitis. Medicine 2017, 96, 5821. [Google Scholar] [CrossRef] [PubMed]
- Tong, Y.; Zheng, L.; Qing, P.; Zhao, H.; Li, Y.; Su, L.; Zhang, Q.; Zhao, Y.; Luo, Y.; Liu, Y.; et al. Oral microbiota perturbations are linked to high risk for rheumatoid arthritis. Front. Cell Infect. Microbiol. 2019, 9, 475. [Google Scholar] [CrossRef] [PubMed]
- Zhao, H.; Chu, M.; Huang, Z.; Yang, X.; Ran, S.; Hu, B.; Zhang, C.; Liang, J. Variations in oral microbiota associated with oral cancer. Sci. Rep. 2017, 7, 11773. [Google Scholar] [CrossRef] [PubMed]
- Xu, H.; Dongari-Bagtzoglou, A. Shaping the oral mycobiota: Interactions of opportunistic fungi with oral bacteria and the host. Curr. Opin. Microbiol. 2015, 26, 65–70. [Google Scholar] [CrossRef] [PubMed]
- Underhill, D.M.; Iliev, I.D. The mycobiota: Interactions between commensal fungi and the host immune system. Nat. Rev. Immunol. 2014, 14, 405–416. [Google Scholar] [CrossRef]
- Ghannoum, M.A.; Jurevic, R.J.; Mukherjee, P.K.; Cui, F.; Sikaroodi, M.; Naqvi, A.; Gillevet, P.M. Characterization of the oral fungal microbiome (mycobiome) in healthy individuals. PLoS Pathog. 2010, 6, 1000713. [Google Scholar] [CrossRef]
- Rank, E.L. Chromogenic agar media in the clinical, food, and environmental testing arenas, part I. Clin. Microbiol. Newsl. 2012, 34, 43–47. [Google Scholar] [CrossRef]
- Tornai-Lehoczki, J.; Peter, G.; Dlauchy, D. CHROMagar Candida medium as a practical tool for the differentiation and presumptive identification of yeast species isolated from salads. Int. J. Food Microbiol. 2003, 86, 189–200. [Google Scholar] [CrossRef]
- Scharmann, U.; Kirchhoff, L.; Chapot, V.L.S.; Dziobaka, J.; Verhasselt, H.L.; Stauf, R.; Buer, J.; Steinmann, J.; Rath, P.M. Comparison of four commercially available chromogenic media to identify Candida albicans and other medically relevant Candida species. Mycoses 2020, 63, 823–831. [Google Scholar] [CrossRef]
- Tu, M.G.; Lin, C.C.; Chiang, Y.T.; Zhou, Z.L.; Lu, J.J.; Hsieh, L.Y.; Chen, K.T.; Chen, M.C.; Lin, H.C.; Sun, P.L.; et al. Distribution of yeast species and risk factors of oral colonization among the residents at nursing homes in Taiwan. J. Dent. Oral Health 2019, 6, 1–15. [Google Scholar]
- Odds, F.C.; Bernaerts, R. CHROMagar Candida, a new differential isolation medium for presumptive identification of clinically important Candida species. J. Clin. Microbiol. 1994, 32, 1923–1929. [Google Scholar] [CrossRef] [PubMed]
- Wang, S.H.; Shen, M.; Lin, H.C.; Sun, P.L.; Lo, H.J.; Lu, J.J. Molecular epidemiology of invasive Candida albicans at a tertiary hospital in northern Taiwan from 2003 to 2011. Med. Mycol. 2015, 53, 828–836. [Google Scholar] [CrossRef] [PubMed][Green Version]
- Lu, J.J.; Lo, H.J.; Wu, Y.M.; Chang, J.Y.; Chen, Y.Z.; Wang, S.H. DST659 genotype of Candida albicans showing positive association between biofilm formation and dominance in Taiwan. Med. Mycol. 2018, 56, 972–978. [Google Scholar] [CrossRef] [PubMed]
- Leaw, S.N.; Chang, H.C.; Sun, H.F.; Barton, R.; Bouchara, J.P.; Chang, T.C. Identification of medically important yeast species by sequence analysis of the internal transcribed spacer regions. J. Clin. Microbiol. 2006, 44, 693–699. [Google Scholar] [CrossRef]
- Al-Sweih, N.; Khan, Z.U.; Ahmad, S.; Devarajan, L.; Khan, S.; Joseph, L.; Chandy, R. Kodamaea ohmeri as an emerging pathogen: A case report and review of the literature. Med. Mycol. 2011, 49, 766–770. [Google Scholar] [CrossRef]
- Powell, H.L.; Sand, C.A.; Rennie, R.P. Evaluation of CHROMagar Candida for presumptive identification of clinically important Candida species. Diagn. Microbiol. Infect. Dis. 1998, 32, 201–204. [Google Scholar] [CrossRef]
- Tavanti, A.; Davidson, A.D.; Gow, N.A.; Maiden, M.C.; Odds, F.C. Candida orthopsilosis and Candida metapsilosis spp. nov. to replace Candida parapsilosis groups II and III. J. Clin. Microbiol. 2005, 43, 284–292. [Google Scholar] [CrossRef]
- Giammanco, G.M.; Melilli, D.; Pizzo, G. Candida pararugosa isolation from the oral cavity of an Italian denture wearer. Res. Microbiol. 2004, 155, 571–574. [Google Scholar] [CrossRef]
- Eraso, E.; Sahand, I.H.; Villar-Vidal, M.; Marcos, C.; Moragues, M.D.; Madariaga, L.; Ponton, J.; Quindos, G. Usefulness of Candida ID2 agar for the presumptive identification of Candida dubliniensis. Med. Mycol. 2006, 44, 611–615. [Google Scholar] [CrossRef]
- Ghelardi, E.; Pichierri, G.; Castagna, B.; Barnini, S.; Tavanti, A.; Campa, M. Efficacy of chromogenic Candida agar for isolation and presumptive identification of pathogenic yeast species. Clin. Microbiol. Infect. 2008, 14, 141–147. [Google Scholar] [CrossRef] [PubMed]
- Pihet, M.; Carrere, J.; Cimon, B.; Chabasse, D.; Delhaes, L.; Symoens, F.; Bouchara, J.P. Occurrence and relevance of filamentous fungi in respiratory secretions of patients with cystic fibrosis—A review. Med. Mycol. 2009, 47, 387–397. [Google Scholar] [CrossRef] [PubMed]
- Thiyahuddin, N.M.; Lamping, E.; Rich, A.M.; Cannon, R.D. Yeast species in the oral cavities of older people: A comparison between people living in their own homes and those in rest homes. J. Fungi 2019, 5, 30. [Google Scholar] [CrossRef] [PubMed]
- De Oliveira Silva, R.B.; Fusco-Almeida, A.M.; Matsumoto, M.T.; Baeza, L.C.; Benaducci, T.; Mendes-Giannini, M.J. Genetic diversity and antifungal susceptibility testing of Trichosporon asahii isolated of intensive care units patients. Braz. J. Microbiol. 2008, 39, 585–592. [Google Scholar] [CrossRef]
- Ward, T.L.; Dominguez-Bello, M.G.; Heisel, T.; Al-Ghalith, G.; Knights, D.; Gale, C.A. Development of the human mycobiome over the first month of life and across body sites. mSystems 2018, 3. [Google Scholar] [CrossRef]
- Sato, T.; Kishi, M.; Suda, M.; Sakata, K.; Shimoda, H.; Miura, H.; Ogawa, A.; Kobayashi, S. Prevalence of Candida albicans and non-albicans on the tongue dorsa of elderly people living in a post-disaster area: A cross-sectional survey. BMC Oral Health 2017, 17, 51. [Google Scholar] [CrossRef]
- Calderone, R.; Suzuki, S.; Cannon, R.; Cho, T.; Boyd, D.; Calera, J.; Chibana, H.; Herman, D.; Holmes, A.; Jeng, H.W.; et al. Candida albicans: Adherence, signaling and virulence. Med. Mycol. 2000, 38, 125–137. [Google Scholar] [CrossRef][Green Version]
- Odds, F.C. Candida and Candidosis: A Review and Bibliography; Bailliere Tindall: London, UK, 1988. [Google Scholar]
- Yang, Y.; Leaw, S.; Wang, A.; Chen, H.; Cheng, W.; Lo, H. Characterization of yeasts colonizing in healthy individuals. Med. Mycol. 2011, 49, 103–106. [Google Scholar] [CrossRef][Green Version]
- Gonsalves, W.C.; Wrightson, A.S.; Henry, R.G. Common oral conditions in older persons. Am. Fam. Phys. 2008, 78, 845–852. [Google Scholar]
- Wu, B.; Hussain, M.; Zhang, W.; Stadler, M.; Liu, X.; Xiang, M. Current insights into fungal species diversity and perspective on naming the environmental DNA sequences of fungi. Mycology 2019, 10, 127–140. [Google Scholar] [CrossRef]
- Sokol, H.; Leducq, V.; Aschard, H.; Pham, H.P.; Jegou, S.; Landman, C.; Cohen, D.; Liguori, G.; Bourrier, A.; Nion-Larmurier, I.; et al. Fungal microbiota dysbiosis in IBD. Gut 2017, 66, 1039–1048. [Google Scholar] [CrossRef] [PubMed]
- Li, J.; Zhao, F.; Wang, Y.; Chen, J.; Tao, J.; Tian, G.; Wu, S.; Liu, W.; Cui, Q.; Geng, B.; et al. Gut microbiota dysbiosis contributes to the development of hypertension. Microbiome 2017, 5, 14. [Google Scholar] [CrossRef] [PubMed]
- Chen, J.; Domingue, J.C.; Sears, C.L. Microbiota dysbiosis in select human cancers: Evidence of association and causality. Semin. Immunol. 2017, 32, 25–34. [Google Scholar] [CrossRef] [PubMed]
- Normand, A.C.; Becker, P.; Gabriel, F.; Cassagne, C.; Accoceberry, I.; Gari-Toussaint, M.; Hasseine, L.; De Geyter, D.; Pierard, D.; Surmont, I.; et al. Validation of a new web application for identification of fungi by use of matrix-assisted laser desorption ionization-time of flight mass spectrometry. J. Clin. Microbiol. 2017, 55, 2661–2670. [Google Scholar] [CrossRef] [PubMed]
- Mortelmaier, C.; Panda, S.; Robertson, I.; Krell, M.; Christodoulou, M.; Reichardt, N.; Mulder, I. Identification performance of MALDI-ToF-MS upon mono-and bi-microbial cultures is cell number and culture proportion dependent. Anal. Bioanal. Chem. 2019, 411, 7027–7038. [Google Scholar] [CrossRef]
- Lasch, P.; Schneider, A.; Blumenscheit, C.; Doellinger, J. Identification of microorganisms by liquid chromatography-mass spectrometry (LC-MS(1)) and in silico peptide mass libraries. Mol. Cell Proteom. 2020, 19, 2125–2138. [Google Scholar] [CrossRef]
- Boulund, F.; Karlsson, R.; Gonzales-Siles, L.; Johnning, A.; Karami, N.; Al-Bayati, O.; Ahren, C.; Moore, E.R.B.; Kristiansson, E. Typing and characterization of bacteria using bottom-up tandem mass spectrometry proteomics. Mol. Cell Proteom. 2017, 16, 1052–1063. [Google Scholar] [CrossRef]
- Kirchhoff, L.; Olsowski, M.; Rath, P.M.; Steinmann, J. Exophiala dermatitidis: Key issues of an opportunistic fungal pathogen. Virulence 2019, 10, 984–998. [Google Scholar] [CrossRef]
- Diaz, P.I.; Hong, B.Y.; Dupuy, A.K.; Strausbaugh, L.D. Mining the oral mycobiome: Methods, components, and meaning. Virulence 2017, 8, 313–323. [Google Scholar] [CrossRef]
- Agwu, E.; Ihongbe, J.C.; McManus, B.A.; Moran, G.P.; Coleman, D.C.; Sullivan, D.J. Distribution of yeast species associated with oral lesions in HIV-infected patients in Southwest Uganda. Med. Mycol. 2012, 50, 276–280. [Google Scholar] [CrossRef]
- Colombo, A.L.; Padovan, A.C.; Chaves, G.M. Current knowledge of Trichosporon spp. and Trichosporonosis. Clin. Microbiol. Rev. 2011, 24, 682–700. [Google Scholar] [CrossRef] [PubMed]
- Urubschurov, V.; Janczyk, P. Biodiversity of yeasts in the gastrointestinal ecosystem with emphasis on its importance for the host. In The Dynamical Processes of Biodiversity-Case Studies of Evolution and Spatial Distribution; IntechOpen: London, UK, 2011. [Google Scholar]



| Yeast Isolates | Numbers | Percent |
|---|---|---|
| Candida | 250 | 78.1% |
| Candida albicans | 129 | 40.3% |
| C. glabrata | 51 | 15.9% |
| C. parapsilosis | 34 | 10.6% |
| C. tropicalis | 22 | 6.9% |
| C. pararugosa | 6 | 1.9% |
| other Candida | 8 | 2.5% |
| Non-Candida | 70 | 21.9% |
| Trichosporon asahii | 18 | 5.6% |
| Trichosporon/Cutaneotrichosporon | 10 | 3.1% |
| Saccharomyces cerevisiae | 7 | 2.2% |
| Meyerozyma guilliermondii | 6 | 1.9% |
| Exophiala dermatitidis | 5 | 1.6% |
| Magnusiomyces capitatus | 5 | 1.6% |
| others | 19 | 5.9% |
| MALDI-TOF MS | Isolate Number | Species |
|---|---|---|
| BioTyper Score ≥ 2.0 | 302 | C. albicans, C. dubliniensis, C. glabrata, C. intermedia, C. krusei, C. metapsilosis, C. orthopsilosis, C. parapsilosis, C. pararugosa, C. tropicalis, Cl. lusitaniae, Cr. neoformans, Cu. mucoides, Cy. jadinii, E. dermatitidis, K. marxianus, Lo. elongisporus, Ma. capitatus, Me. guilliermondii, P. manshurica, P. norvegensis, R. mucilaginosa, R. toruloides, S. cerevisiae, T. asahii, T. faecale |
| 2.0 > BioTyper Score between ≥ 1.8 | 8 | |
| Agree with ITS sequencing results | ||
| Agree with morphology on CHROMagar | 5 | C. orthopsilosis, E. dermatitidis, S. cerevisiae, T. faecale |
| Disagree with morphology on CHROMagar | 1 | Pichia manshurica |
| Disagree with ITS sequencing results | ||
| Agree with morphology on CHROMagar | 2 | Me. guilliermondii var. membranifaciens (ITS: Kodamaea ohmeri) |
| Disagree with morphology on CHROMagar | 0 | |
| BioTyper Score < 1.8 | 4 | |
| Agree with ITS sequencing results | ||
| Agree with morphology on CHROMagar | 1 | Cu. jirovecii |
| No CHROMagar morphology information available | 2 | La. fermentati |
| Disagree with ITS sequencing results | ||
| No CHROMagar morphology information available | 1 | C. fermentati (teleomorph Meyerozyma caribbica) |
| Candida Species | Isolates (Total 320) | Morphology | Colony Color | Frequency of Regular Type |
|---|---|---|---|---|
| Candida albicans | 129 (40.3%) | ![]() | Light green | 100% (129/129) |
| Candida glabrata | 51 (15.9%) | ![]() | Purple | 100.0% (51/51) |
| Candida parapsilosis | 34 (10.6%) | ![]() | White (regular) Purple (few) | 94.1% (32/34) |
| Candida tropicalis | 22 (6.9%) | ![]() | Metallic blue (regular) Dark green (few) | 90.9% (20/22) |
| Candida guilliermondii | 6 (1.9%) | ![]() | Light purple | 100% (6/6) |
| Candida pararugosa | 6 (1.9%) | ![]() | Purple (regular) Pale pink (few) | 66.7% (4/6) |
| Yeast Species | Isolates (Total 320) | Morphology | Colony Color | Frequency of Regular Type |
|---|---|---|---|---|
| Trichosporon asahii | 18 (5.6%) | ![]() | Light blue | 100% (18/18) |
| Cutaneotrichosporon mucoides | 6 (1.9%) | ![]() | Light purple | 100% (6/6) |
| Saccharomyces cerevisiae | 7 (2.2%) | ![]() | Purple | 100% (7/7) |
| Exophiala dermatitidis | 5 (1.6%) | ![]() | Greenish brown | 100% (5/5) |
| Magnusiomyces capitatus | 5 (1.6%) | ![]() | Pale pink | 100% (5/5) |
| Color Group | Isolate Number | Final ID | Regular Color | Color-Matched | % In Total (311) | % In Color Group |
|---|---|---|---|---|---|---|
| Green | 130 | Candida albicans | green | 129 | 41.5% | 99.2% |
| Candida dubliniensis | dark green | 1 | 0.3% | 0.8% | ||
| Purple/Pink | 90 | Candida glabrata | purple | 51 | 16.4% | 56.7% |
| Saccharomyces cerevisiae | purple | 7 | 2.3% | 7.8% | ||
| Cutaneotrichosporon mucoides | light purple | 6 | 1.9% | 6.7% | ||
| Magnusiomyces capitatus | pale pink | 5 | 1.6% | 5.6% | ||
| Candida pararugosa | very light purple | 4 | 1.3% | 4.4% | ||
| Meyerozyma guilliermondii | light purple | 4 | 1.3% | 4.4% | ||
| Pichia kudriavzevii | purple with white border | 4 | 1.3% | 4.4% | ||
| Pichia manshurica | pale pink | 2 | 0.6% | 2.2% | ||
| Candida ethanolica | pale pink with white border | 1 | 0.3% | 1.1% | ||
| Candida fermentati | light purple | 1 | 0.3% | 1.1% | ||
| Candida intermedia | dark purple | 1 | 0.3% | 1.1% | ||
| Candida metapsilosis | light purple | 1 | 0.3% | 1.1% | ||
| Clavispora lusitaniae | light purple | 1 | 0.3% | 1.1% | ||
| Cyberlindnera jadinii | light purple | 1 | 0.3% | 1.1% | ||
| Kluyveromyces marxianus | light purple | 1 | 0.3% | 1.1% | ||
| Blue | 42 | Candida tropicalis | metallic blue | 20 | 6.4% | 47.6% |
| Trichosporon asahii | blue | 18 | 5.8% | 42.9% | ||
| Trichosporon faecale | blue | 2 | 0.6% | 4.8% | ||
| Cutaneotrichosporon jirovecii | blue | 1 | 0.3% | 2.4% | ||
| Lodderomyces elongisporus | metallic blue | 1 | 0.3% | 2.4% | ||
| White | 38 | Candida parapsilosis | white | 32 | 10.3% | 84.2% |
| Candida orthopsilosis | white | 3 | 1.0% | 7.9% | ||
| Pichia norvegensis | white | 2 | 0.6% | 5.3% | ||
| Cryptococcus neoformans | milk white | 1 | 0.3% | 2.6% | ||
| Gray | 7 | Exophiala dermatitidis | olivaceous-gray | 5 | 1.6% | 71.4% |
| Fereydounia khargensis | olivaceous-gray | 2 | 0.6% | 28.6% | ||
| Orange | 4 | Lachancea fermentati | red-brown | 2 | 0.6% | 50.0% |
| Rhodotorula mucilaginosa | orange | 1 | 0.3% | 25.0% | ||
| Rhodotorula toruloides | orange | 1 | 0.3% | 25.0% |
Publisher’s Note: MDPI stays neutral with regard to jurisdictional claims in published maps and institutional affiliations. |
© 2021 by the authors. Licensee MDPI, Basel, Switzerland. This article is an open access article distributed under the terms and conditions of the Creative Commons Attribution (CC BY) license (http://creativecommons.org/licenses/by/4.0/).
Share and Cite
Lu, J.-J.; Lo, H.-J.; Lee, C.-H.; Chen, M.-J.; Lin, C.-C.; Chen, Y.-Z.; Tsai, M.-H.; Wang, S.-H. The Use of MALDI-TOF Mass Spectrometry to Analyze Commensal Oral Yeasts in Nursing Home Residents. Microorganisms 2021, 9, 142. https://doi.org/10.3390/microorganisms9010142
Lu J-J, Lo H-J, Lee C-H, Chen M-J, Lin C-C, Chen Y-Z, Tsai M-H, Wang S-H. The Use of MALDI-TOF Mass Spectrometry to Analyze Commensal Oral Yeasts in Nursing Home Residents. Microorganisms. 2021; 9(1):142. https://doi.org/10.3390/microorganisms9010142
Chicago/Turabian StyleLu, Jang-Jih, Hsiu-Jung Lo, Chih-Hua Lee, Mei-Jun Chen, Chih-Chao Lin, Yin-Zhi Chen, Ming-Horng Tsai, and Shao-Hung Wang. 2021. "The Use of MALDI-TOF Mass Spectrometry to Analyze Commensal Oral Yeasts in Nursing Home Residents" Microorganisms 9, no. 1: 142. https://doi.org/10.3390/microorganisms9010142
APA StyleLu, J.-J., Lo, H.-J., Lee, C.-H., Chen, M.-J., Lin, C.-C., Chen, Y.-Z., Tsai, M.-H., & Wang, S.-H. (2021). The Use of MALDI-TOF Mass Spectrometry to Analyze Commensal Oral Yeasts in Nursing Home Residents. Microorganisms, 9(1), 142. https://doi.org/10.3390/microorganisms9010142